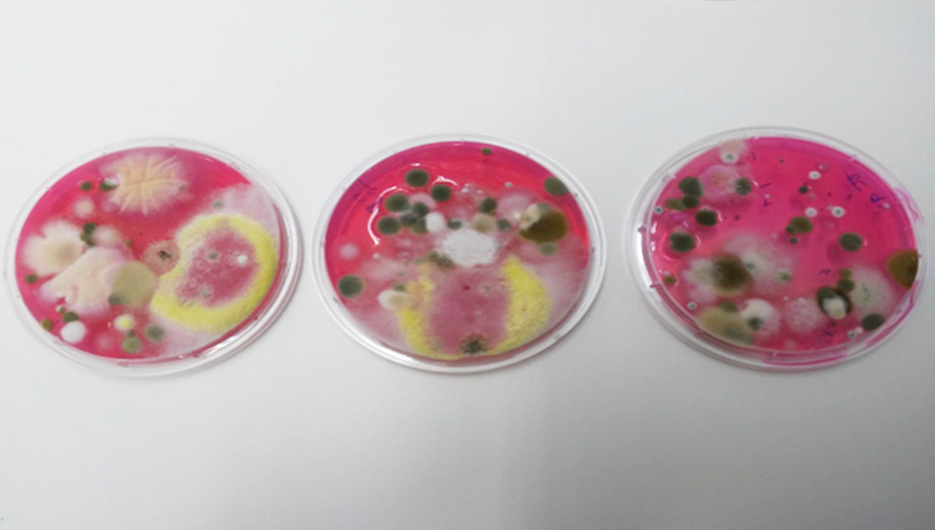
fruta

We are already in summer and the date is approaching to pick the fruit that will go to the refrigerated chambers for distribution during the fall and winter. In the case of the conference pear, the size, color and texture are examined to proceed to its collection and storage in cold storage. From the time the pears are harvested until they reach the consumer, Rincón pears go through different steps, all the agents involved are very important and have to keep the fruit in the best conditions since contamination by fungi is easy at any point in the chain.
For this reason, fruit warehouses, one of the most important agents, are finalizing the last cleaning and disinfection of crates, warehouses and storage chambers. This work is very necessary because the fruit will spend a long season in controlled atmosphere chambers until it is distributed and reaches the consumer.
As in other campaigns, Clean-Biotec checks the quality of the disinfections of crates and chambers with routine air and surface controls. The Clean-Biotec team goes to the facilities and carries out an inspection of the different critical points in the warehouse, takes samples with contact plates with specific medium for fungi and cultures them in the laboratory. They give the results to the warehouse technician, who ensures that the crates are ready for picking the conference pear and the chambers are free of fungi for storage.
Clean-Biotec with its controls guarantees the quality of the facilities for the collection and storage of fruit, determining the possible fungi that could appear and looking for biological solutions for their treatment.


